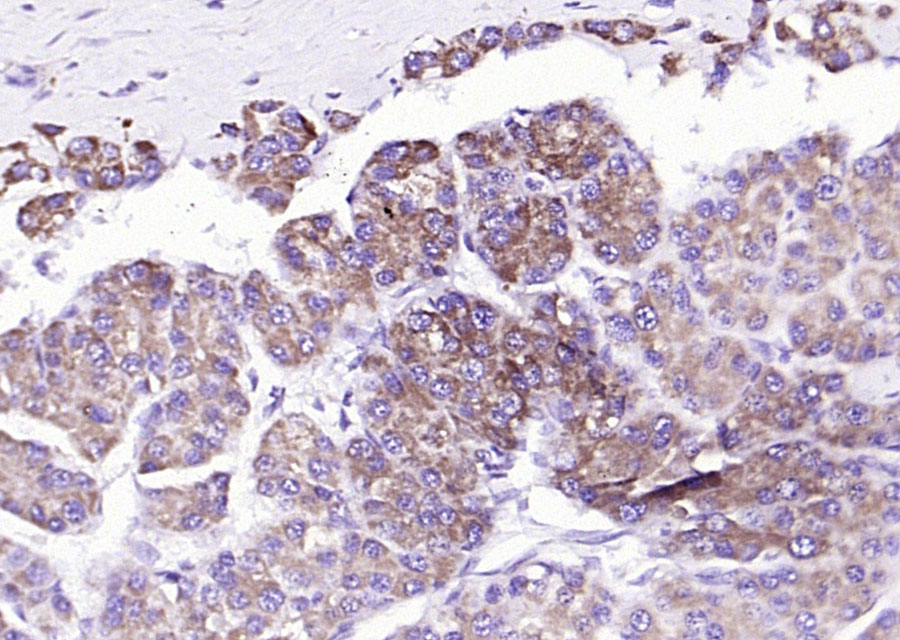
肝脏型脂肪酸结合蛋白抗体-bs-0897R
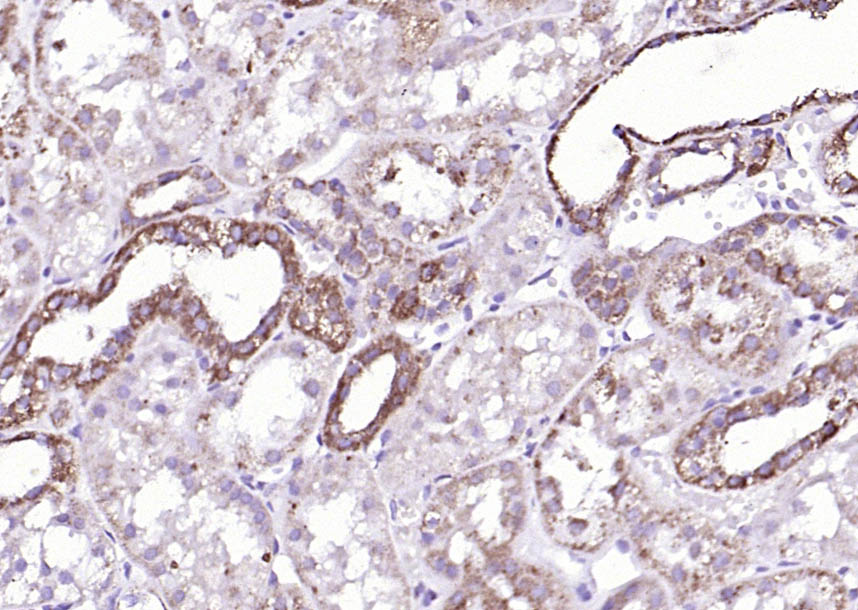
肝脏型脂肪酸结合蛋白抗体-bs-0897R

liver FABP Rabbit pAb (一抗) | Bioss

货号:bs-0897R
产品详情
相关标记
相关产品
相关文献
常见问题
概述
产品编号
bs-0897R
产品类型
农牧业/家禽抗体
英文名称
liver FABP Rabbit pAb
中文名称
肝脏型脂肪酸结合蛋白抗体
英文别名
FABPL; L-FABP; Fabplg; SCP; SCP.; p14; FABPL_HUMAN; FABP1; Fatty acid-binding protein 1; Liver-type fatty acid-binding protein (L-FABP); FABPL_MOUSE; 14 kDa selenium-binding protein; FABPL_RAT; Squalene- and sterol-carrier protein (SCP); Z-protein;
抗体来源
Rabbit
免疫原
KLH conjugated synthetic peptide derived from chicken LFABP: 21-127/127
亚型
IgG
性状
Liquid
纯化方法
affinity purified by Protein A
克隆类型
Polyclonal
理论分子量
14 kDa
浓度
1mg/ml
储存液
0.01M TBS (pH7.4) with 1% BSA, 0.02% Proclin300 and 50% Glycerol.
研究领域
保存条件
Shipped at 4℃. Store at -20℃ for one year. Avoid repeated freeze/thaw cycles.
注意事项
This product as supplied is intended for research use only, not for use in human, therapeutic or diagnostic applications.
数据库链接
产品介绍
肝脏型脂肪酸结合蛋白家族是脂质结合蛋白超家族成员,是一族多源性的小分子多肽蛋白,存在于脊椎动物和非脊椎动物的细胞内,在细胞内长链脂肪酸的摄取、转运及代谢调节中发挥着重要作用。
LFABP广泛存在于哺乳动物的小肠、肝、心、脑、骨骼肌等多种细胞内,其主要作用是调节脂肪酸的摄取和胞内运输,可将脂肪酸从细胞膜上运送到脂肪酸氧化和甘油三酯及磷脂合成的场所。
LFABP广泛存在于哺乳动物的小肠、肝、心、脑、骨骼肌等多种细胞内,其主要作用是调节脂肪酸的摄取和胞内运输,可将脂肪酸从细胞膜上运送到脂肪酸氧化和甘油三酯及磷脂合成的场所。
背景资料
This gene encodes the fatty acid binding protein found in liver. Fatty acid binding proteins are a family of small, highly conserved, cytoplasmic proteins that bind long-chain fatty acids and other hydrophobic ligands. This protein and FABP6 (the ileal fatty acid binding protein) are also able to bind bile acids. It is thought that FABPs roles include fatty acid uptake, transport, and metabolism. [provided by RefSeq, Mar 2011]

产品应用
| 应用 | 已检合格种属 | 预测种属 | 推荐稀释比例 |
|---|---|---|---|
| IHC-P | Human, Mouse, Rat | Pig, Chicken | 1:100-500 |
| IHC-F | Human, Mouse, Rat | Pig, Chicken | 1:100-500 |
| IF | Human, Mouse, Rat | Pig, Chicken | 1:100-500 |
交叉反应
交叉反应: Human, Mouse, Rat (predicted: Pig, Chicken)
相关产品
暂无相关产品
靶标
基因名
FABP1
蛋白名
Fatty acid-binding protein, liver
亚细胞定位
Cytoplasm.
相似性
Belongs to the calycin superfamily. Fatty-acid binding protein (FABP) family.
功能
Binds free fatty acids and their coenzyme A derivatives, bilirubin, and some other small molecules in the cytoplasm. May be involved in intracellular lipid transport.
同靶标产品
相关文献
提示: 发表研究结果有使用 bs-0897R 时请让我们知道,以便我们可以引用参考文章。作为回馈,资料提供者将获得我们送上的小礼品。
具体参考文献:bs-0897R 被引用于2文献中